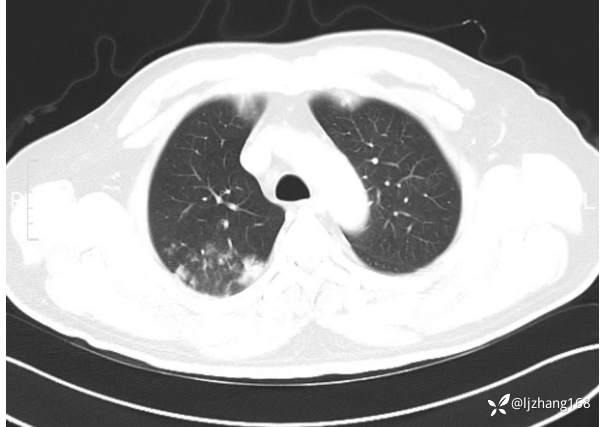
img
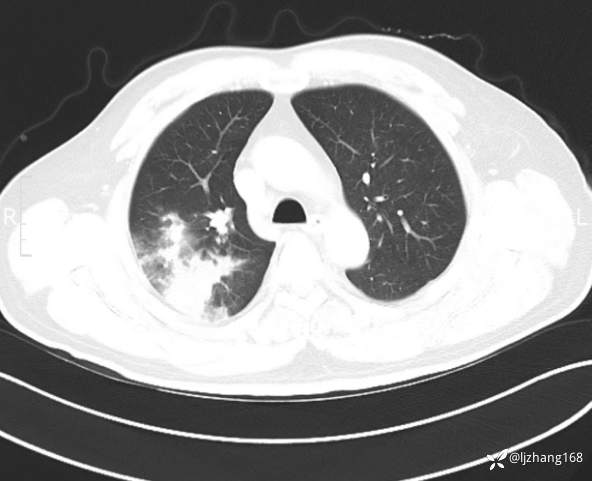
img
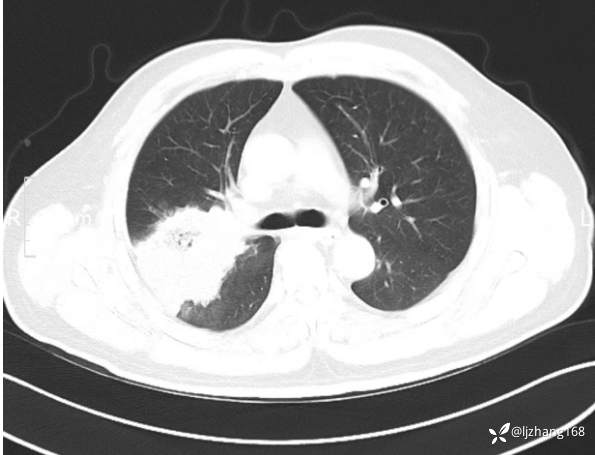
img
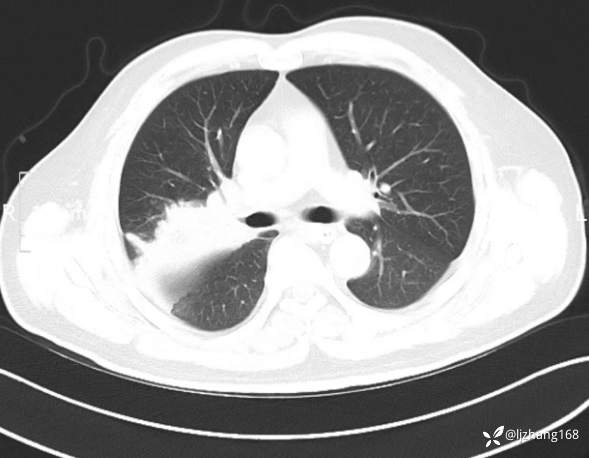
img
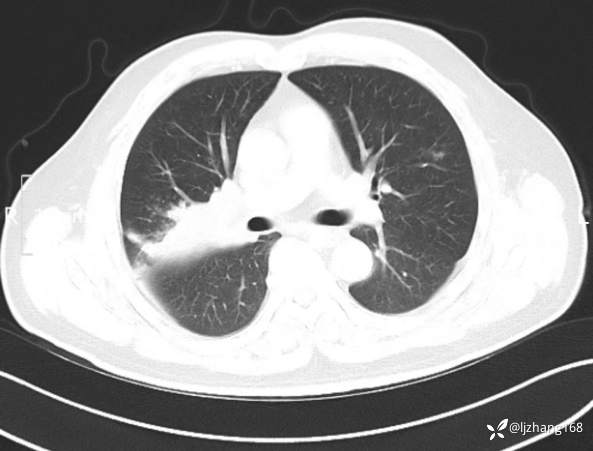
img
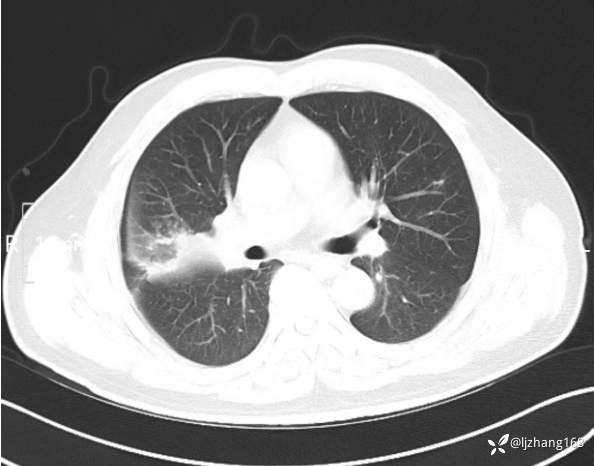
img
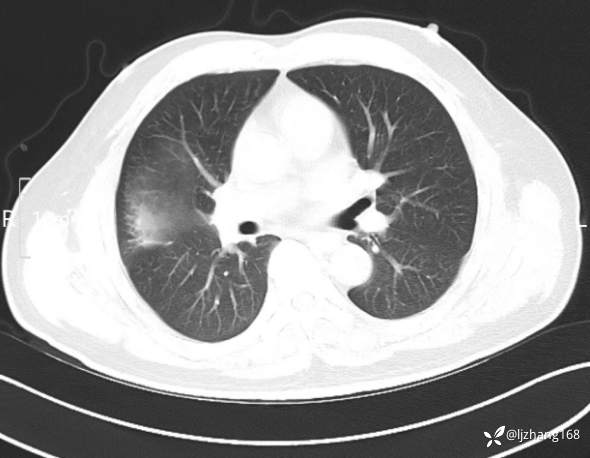
img
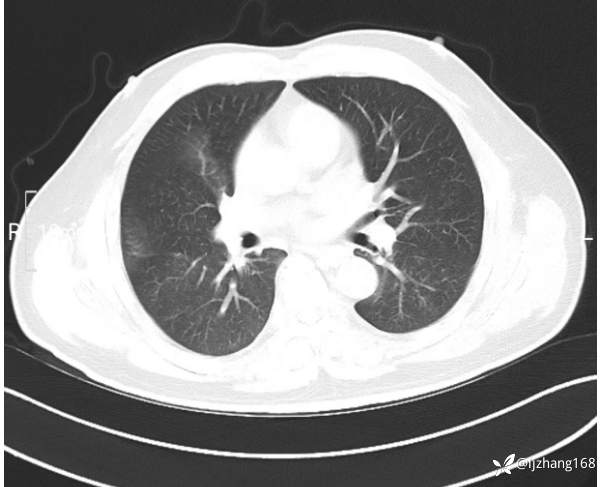
img
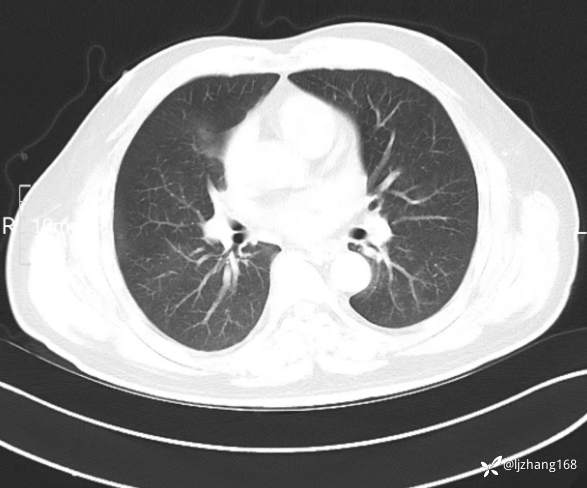
img
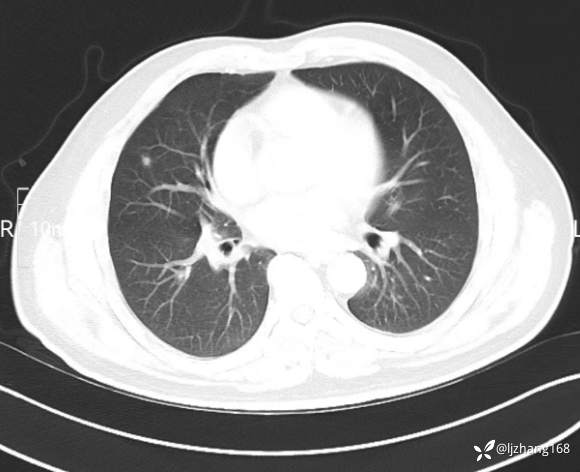
img
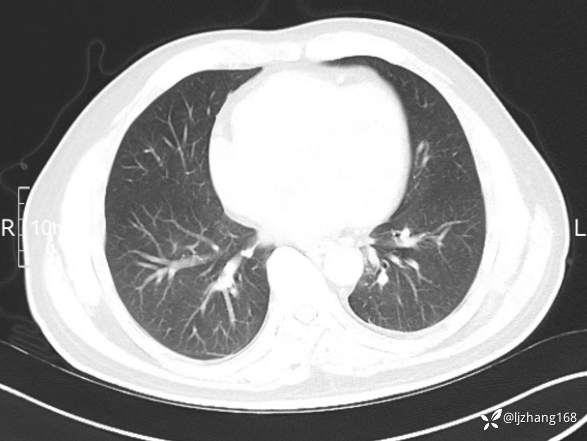
img

中年男患,右肺团片影,炎症0R肿瘤?
患者性别:男
患者年龄:47岁
主诉:咳嗽、 咳痰伴气短20+天
简要病史: 20+天前患者因受凉后出现阵发性咳嗽,咳少量白色粘痰,痰易咳出,伴活动后气短,伴纳差、乏力、全身酸痛,伴多汗,无痰中带血及咯血,无发热、畏寒及寒战,无潮热、盗汗,无夜间阵发性呼吸困难及端坐呼吸,无声嘶,无头晕、头痛,无黑矇、晕厥及意识障碍,无腹痛、呕血及黑便等不适,遂就诊于当地医院予以输液等治疗后未见明显好转(具体诊疗不详),现为进一步诊治就诊于我院门诊,以“右肺占位”收入我科。病来饮食欠佳,近期体重下降(具体不详)。既往糖尿病病史7+年,未规律监测血糖,血糖控制不佳。否认“高血压、冠心病及慢性肾脏病”等慢性疾病史。否认“肝炎、结核、伤寒”等传染病史。否认食物、药物过敏史。否认外伤、输血史,预防接种史不详。
体格检查:T 36.4℃ P 110次/分 R 23次/分 BP 131/75mmHg。 自主体位,安静面容,神清合作,全身表浅淋巴结未触及,口唇无发绀,颈静脉无充盈,肝颈静脉回流征阴性。咽部未见充血、红肿,扁桃体不大,胸廓正常,双下肺叩诊清音,双肺呼吸音稍粗,右肺闻及少许湿性啰音,左肺未闻及湿性啰音,未闻及哮鸣音及胸膜摩擦音; 心界不大,心率110次/分,律齐,心尖部心音有力,各瓣膜听诊区未闻及杂音。腹软,无压痛、反跳痛及肌紧张,肝脾未及,移动性浊音阴性。双下肢不肿,神经系统未见明显阳性体征。
辅助检查:糖化血红蛋白12.3%。肺炎支原体IgG、IgM、呼吸道合胞病毒均未见明显异常。胸部CT:右肺上叶阻塞性肺炎。
临床诊断:
治疗经过:
讨论:诊断及鉴别

最后编辑于 2024-02-08 · 浏览 1745